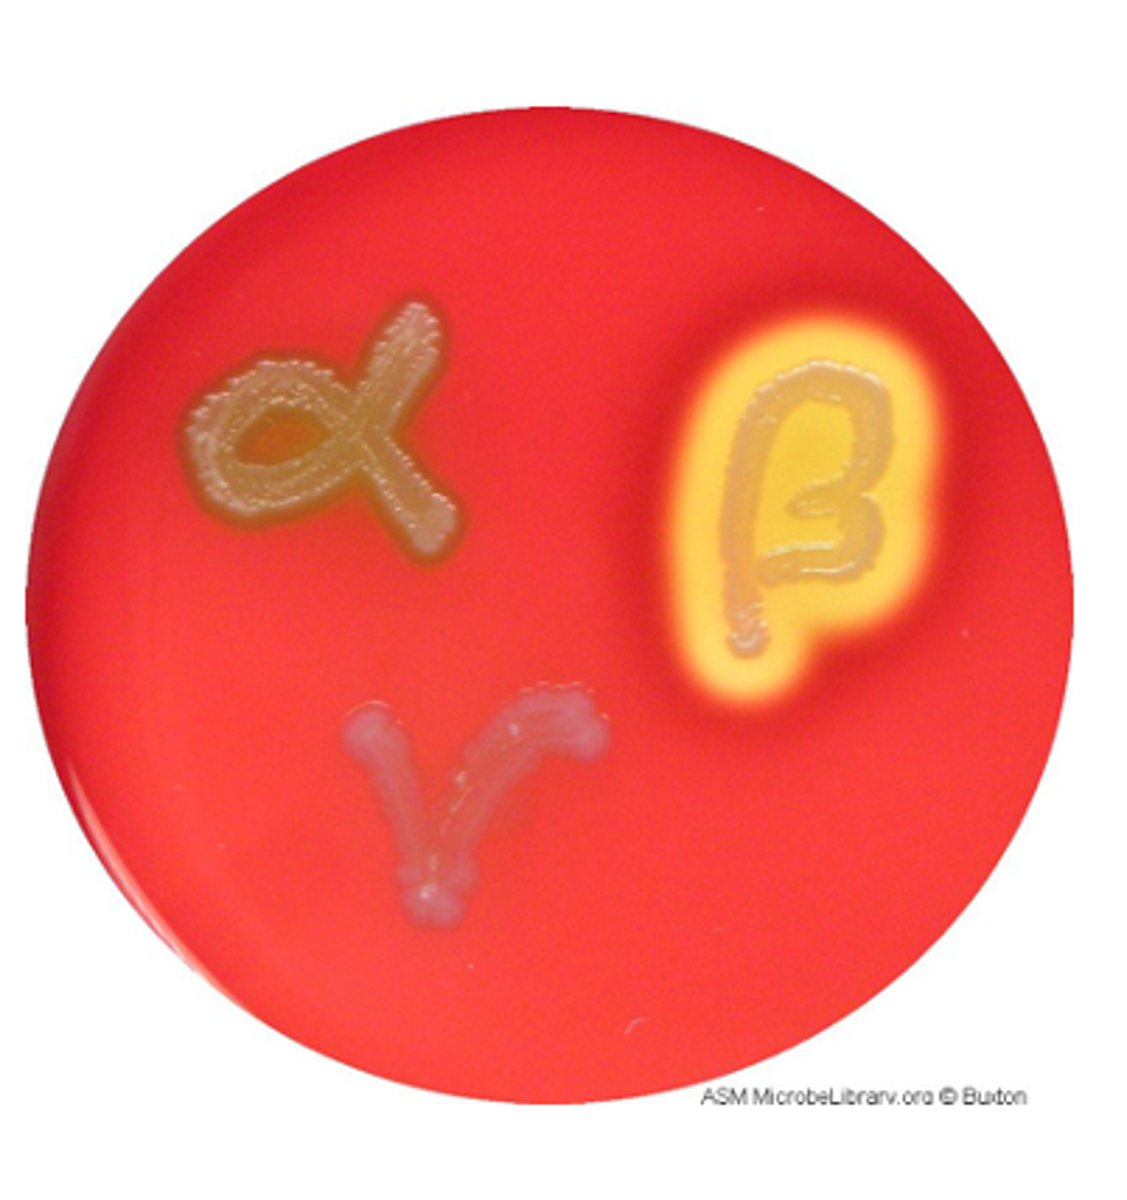
<p>Complete lysis of red blood cells with clear zone</p>
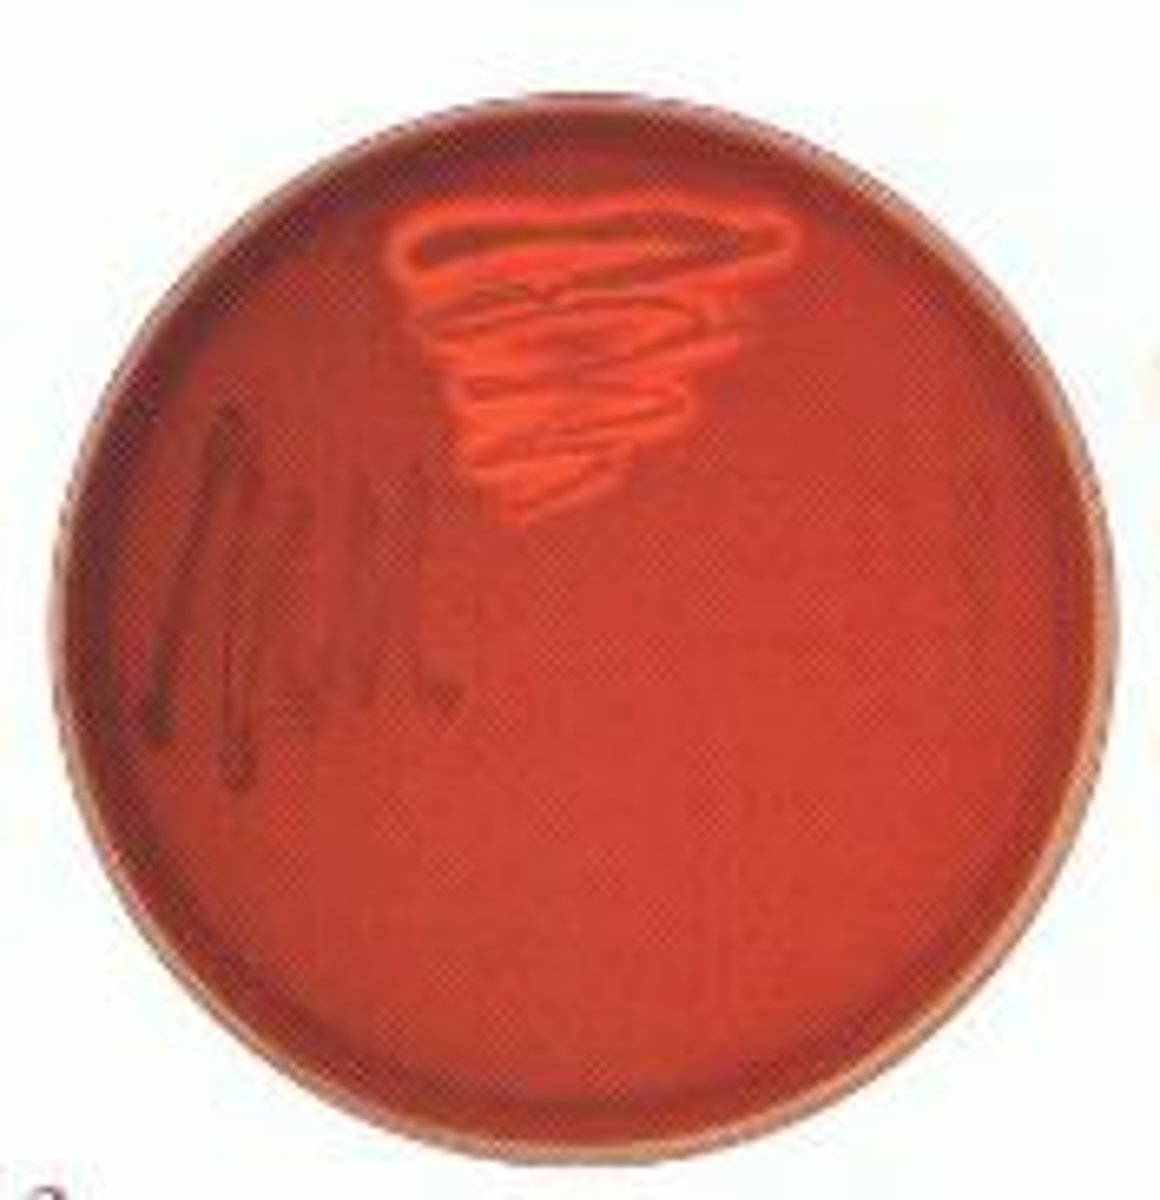
<p>Colistin (polymyxin B) and nalidixic acid</p>

Selective and Differential Media
1/41
There's no tags or description
Looks like no tags are added yet.
Name | Mastery | Learn | Test | Matching | Spaced | Call with Kai |
|---|
No analytics yet
Send a link to your students to track their progress
42 Terms
What type of bacteria does enriched media support?
Fastidious bacteria
What do enriched media provide to support growth?
Complex growth factors (blood or serum)

What do selective media contain?
Inhibitory substances (antibiotics, dyes, or salts)

What is the purpose of selective media?
Suppress one group of bacteria while allowing others to grow

What do differential media distinguish bacteria based on?
Biochemical (metabolic) differences

Blood agar is enriched because it contains what?
5% sheep blood (growth factors)

Blood agar differentiates bacteria based on what?
Hemolysis of red blood cells

What is beta hemolysis?
Complete lysis of red blood cells with clear zone
What is alpha hemolysis?
Partial lysis producing greenish discoloration

What is gamma hemolysis?
No hemolysis (no change in medium)

Columbia CNA agar selects for which bacteria?
Gram-positive bacteria

What antibiotics make Columbia CNA selective?
Colistin (polymyxin B) and nalidixic acid
Columbia CNA differentiates bacteria based on what?
Hemolysis

MacConkey agar is selective because it contains what?
Crystal violet and bile salts

MacConkey agar selects for which organisms?
Enteric Gram-negative bacteria

MacConkey differentiates bacteria based on what?
Lactose fermentation

What pH indicator does MacConkey use?
Neutral red

What color indicates lactose fermentation on MacConkey?
Pink or red colonies

What color indicates non-lactose fermentation on MacConkey?
Colorless colonies

What enzyme is required for lactose fermentation?
Beta-galactosidase (lactase)

EMB agar is selective because it contains what dyes?
Eosin and methylene blue

EMB differentiates bacteria based on what?
Lactose fermentation and acid production

What indicates high acid production with strong lactose fermenter on EMB?
Green metallic sheen

What indicates low acid production with weak lactose fermenter on EMB?
Pink colonies

What indicates a non-lactose fermenter on EMB?
Colorless colonies

MSA is selective because it contains what?
7.5% sodium chloride (high salt)
MSA selects for what type of organisms?
Halotolerant organisms (e.g., Staphylococcus)
MSA differentiates bacteria based on what?
Mannitol fermentation
What pH indicator does MSA use?
Phenol red
What color indicates mannitol fermentation on MSA?
Yellow
What color indicates no mannitol fermentation on MSA?
Red/ Pink
Mueller-Hinton agar is primarily used for what?
Antibiotic susceptibility testing (Kirby-Bauer method)
Bacteria preferentially metabolize what carbon source first?
Carbohydrates
If carbohydrates are unavailable, bacteria metabolize what?
Proteins
Carbohydrate fermentation produces what type of byproducts?
Acidic end-products (lower pH)
Protein metabolism produces what type of byproducts?
Amine-containing basic waste (raises pH)
If glucose and lactose are both present, which is used first?
Glucose
What metabolic principle explains glucose preference?
Catabolite repression
pH changes in differential media reflect what?
Secreted metabolic waste products
What defines selective media?
Inhibitory agents that suppress certain bacteria
What defines differential media?
Substrate plus indicator to detect metabolism
What defines enriched media?
Added growth factors to support fastidious organisms